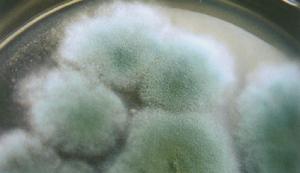
木酶

介紹
木酶
木酶木黴菌落開始時為白色,緻密,圓形,向四周擴展,後從菌落中央產生綠色孢子,中央變成綠色。菌落周圍有白色菌絲的生長帶。最後整個菌落全部變成綠色。綠色木黴菌絲白色,纖細,寬度為1.5~2.4微米。產生分生孢子。分生孢子梗垂直對稱分歧,分生孢子單生或簇生,圓形,綠色。綠色木黴菌落外觀深綠或藍綠色;康氏木黴菌落外觀淺綠、黃綠或綠色。
綠色木霉適應性很強,孢子在PDA培養基平板上24℃時萌發,菌落迅速擴展。培養2天,菌落直徑為3.5~5.0厘米;培養3天,菌落直徑為7.3~8.0厘米;培養4天,菌落直徑為8.1~9.0厘米。
通常菌落擴展很快,特別在高溫高濕條件下幾天內木黴菌落可遍布整個料面。菌絲生長溫度4—42℃,25—30℃生長最快,孢子萌發溫度10—35℃,15—30℃萌發率最高,25—27℃菌落由白變綠只需4—5晝夜,高溫對菌絲生長和萌發有利。孢子萌發要求相對濕度95%以上,但在乾燥環境也能生長,菌絲生長pH值為3.5~5.8,在pH值4~5條件下生長最快。
木霉具有較強分解纖維素能力,綠色木霉通常能夠高度活性的纖維素酶,對纖維素的分解能力很強。在木質素、纖維素豐富的基質上生長快,傳播蔓延迅速。棉籽殼。木屑、段木都是其良好的營養物。
食用菌木霉的危害性
危害症狀木霉的主要生物特徵為其菌絲成熟期很短,往往在一周內即可達到生理成熟,然後即生出綠色霉層,即其孢子層。當基料被侵染後,菌絲階段不易察覺,直到出現霉層時才能引起注意;起初只是點狀或斑塊狀,當條件合適或食用菌菌絲不很健壯時,很快發展為片狀,直至污染整個菌袋或料床,若不及時採取措施,菇棚內短時間即可成一片綠色,其孢子飛揚,周邊棚牆上也將附著大量木霉孢子,給以後的生產留下嚴重隱患。
發生規律木霉主要生存在朽木、枯枝落葉、土壤、有機肥、植物殘體上和空氣中。許多栽培的老菇房,帶菌的菇具和場所是主要的初侵染源,已發病所產生的分生孢子,可多次重複侵染更為頻繁。木霉發病率的高低與環境條件的關係較大,木霉孢子在15-30`C下萌發率較高,菌絲體在4-42`C的溫度下均能生長,在25-30`C生長最快。孢子在空氣相對濕度95%的條件下,萌發最快,相對濕度低於85%較難萌發。因此,在高溫、高濕、通氣不良和培養料呈偏酸性時,很容易滋生木霉。木霉侵染寄主後,與寄主爭奪養分和空間,同時還分泌毒素殺傷、殺死寄主,把寄主的菌絲纏繞、切斷。
防治措施
(1)制種或熟料栽培拌料時按比例加入1:1000倍疣霉淨,並嚴格滅菌,以徹底殺死其孢子。
(2)科學調配基料組分,使營養全面、均衡,以保證食用菌菌絲的健康和抗性,可對黴菌形成拮抗或抑制。實踐證明,生產中按比例加入天天菇耳壯即可。
(3)發酵栽培時,加入疣霉淨後,基料仍要發酵均勻,儘可能多的殺死或抑制其孢子。
(4)接種操作要嚴格、規範,不使黴菌孢子落於料中。研究發現,接種時,開啟食用菌接種淨化機5min後再進行操作,生產效果與常規甲醛熏蒸相仿,並且,杜絕了甲醛對人體的刺激,避免了甲醛殘留的可能。
(5)菌種或菌袋發菌以及出菇期間,每5天左右對菇棚空閒處噴灑30-50倍金星消毒液或1:1000倍疣霉淨,是目前最有效的預防方法。
(6)發現木霉後,及時用1:500倍疣霉淨噴灑或注射、塗抹污染區和菌袋,效果顯著,污染嚴重的菌袋要及時作焚燒或深埋處理。
